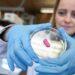
Lab-grown meat: Could Australia change its laws for this 'cell-based' poultry option? | SBS News

Urban centers worldwide are embracing smart city technologies to combat climate change, with innovative solutions reducing carbon footprints by up to 40% in pioneering municipalities. This transformative approach merges cutting-edge IoT systems, renewable energy integration, and AI-powered infrastructure to create sustainable urban ecosystems. Our comprehensive analysis reveals how these technological advancements are reshaping cities into climate-friendly hubs while improving quality of life for millions of residents.
The Climate Imperative for Smart Cities
With urban areas responsible for:
-
70% of global CO₂ emissions
-
60% of resource consumption
-
75% of energy usage
Smart city initiatives have become critical in achieving:
✔️ Paris Agreement climate targets
✔️ UN Sustainable Development Goals
✔️ Net-zero urban planning objectives
A. Core Smart Technologies Reducing Emissions
A. Intelligent Energy Grids
-
Real-time demand-response systems
-
Distributed renewable energy integration
-
Predictive maintenance for efficiency
B. Smart Mobility Solutions
-
EV charging infrastructure networks
-
AI-optimized traffic light systems
-
Mobility-as-a-Service (MaaS) platforms
C. Building Automation Systems
-
IoT-enabled HVAC optimization
-
Dynamic lighting controls
-
Energy-positive skyscrapers
D. Waste Management Innovations
-
Smart bins with fill-level sensors
-
AI-powered sorting facilities
-
Waste-to-energy conversion plants
E. Urban Green Infrastructure
-
Vertical forests and green roofs
-
Smart irrigation systems
-
Air quality monitoring networks
B. Global Leaders in Carbon-Cutting Smart Cities
A. Copenhagen, Denmark
-
Targeting carbon neutrality by 2025
-
District heating system serving 98% of city
-
Smart bike lanes with priority signaling
B. Singapore
-
“City in a Garden” initiative
-
Automated underground waste system
-
World’s largest urban solar project
C. Amsterdam, Netherlands
-
Circular economy implementation
-
Smart canal boats for waste collection
-
Energy-sharing neighborhoods
D. San Francisco, USA
-
Zero-waste program achieving 80% diversion
-
Smart water metering saving 15% in usage
-
EV adoption incentives
C. Measurable Climate Impact
Documented Reductions in Pilot Cities:
| Technology | Emission Reduction | Energy Savings |
|---|---|---|
| Smart Grids | 25% | 30% |
| Intelligent Transport | 20% | 22% |
| Building Automation | 35% | 40% |
| Waste Tech | 15% | 18% |
D. Implementation Challenges
A. Financial Barriers
-
High upfront infrastructure costs
-
ROI timeline uncertainties
B. Technological Hurdles
-
Legacy system integration issues
-
Cybersecurity vulnerabilities
C. Social Considerations
-
Digital divide concerns
-
Privacy implications of surveillance
D. Policy Limitations
-
Regulatory framework gaps
-
Jurisdictional coordination needs
E. Future Innovations in Development
A. Next-Gen Urban Solutions
-
Carbon-absorbing building materials
-
AI-powered microclimate management
-
Underground urban logistics networks
B. Emerging Technologies
-
Vehicle-to-grid energy systems
-
Digital twin city simulations
-
Autonomous delivery ecosystems
C. Global Scaling Strategies
-
Modular implementation approaches
-
Developing nation adaptations
-
Public-private partnership models
Actionable Steps for Cities
Phase 1: Foundation (Years 0-2)
-
Deploy IoT sensors for baseline data
-
Implement quick-win pilot projects
-
Establish cross-departmental task force
Phase 2: Expansion (Years 3-5)
-
Scale successful pilots citywide
-
Integrate systems into unified platform
-
Launch citizen engagement programs
Phase 3: Optimization (Years 5-10)
-
AI-driven predictive analytics
-
Continuous improvement cycles
-
Knowledge sharing with other cities
Conclusion
Smart city technologies present our most viable pathway to sustainable urbanization, with current implementations proving significant carbon reductions are achievable. As innovations mature and costs decline, these solutions will become the global standard for urban development, offering a blueprint for harmonizing technological progress with environmental stewardship.